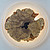

Бра Iluka London Halo Wall Light
PS1049924 |
|
| Производитель: | Iluka London (Великобритания) |
|
цена по запросу
Добавить в заказ
Для чего это нужно? Предварительный заказ с сайта позволяет максимально быстро отправить заявку менеджеру компании на создание коммерческого предложения с подробным расчётом стоимости, указанием возможных скидок и сроков поставки оборудования. Получить скидку 44-ФЗ и 223-ФЗ Нашли дешевле? Бесплатная доставка |
|
| Все характеристики | |
| Материал: | эвкалипт/смола |
| Источник света: | LED |
| Тип монтажа: | настенное |
| Диаметр: | 420 мм |
| Глубина: | 70 мм |